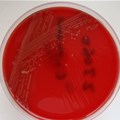
A lab sample of the bacteria listeria monocytogene that causes listeriosis.

Subscribe to daily business and company news across 19 industries
×News


Circular Economy & Waste Management
CapeNature’s new campaign tackles pollution in the Cape

Circular Economy & Waste Management
Plastic microbeads: great in your face wash, bad in your food – how South Africa’s ban can work better

Circular Economy & Waste Management
2025 Petco Awards: Meet the women driving South Africa’s circular economy


Circular Economy & Waste Management
Circular economy takes centre stage with new eco-friendly housing initiative in South Africa

Circular Economy & Waste Management
SA's solar boom poses new environmental threat: What to do with your old Li-ion batteries




Circular Economy & Waste Management
2,000 new waste management job opportunities in Mbombela


Circular Economy & Waste Management
The war on waste needs strong partnerships

Circular Economy & Waste Management
Rwanda leads Africa in plastic waste management


Circular Economy & Waste Management
Unemployed women turn rubbish dump into netball field for young girls

Circular Economy & Waste Management
Activists and learners clean up Mfuleni, Cape Town wetland


Circular Economy & Waste Management
What is pay-as-you-throw? A waste expert explains



Circular Economy & Waste Management
Filthy Mthatha is a pigsty, say residents

Circular Economy & Waste Management
Local study finds ships a major source of litter on SA beaches


Circular Economy & Waste Management
Johannesburg is threatening to sideline informal waste pickers. Why it's a bad idea

NGO, NPO & Social Enterprise
Litter4Tokens founder awarded 2 Stevie Awards for Women in Business

Food & bev. services
#YouthMonth: Jozi lovebirds blossom into business owners




Circular Economy & Waste Management
City of Joburg spends Mandela Day cleaning up Orlando West

Circular Economy & Waste Management
Biggest pollutants on SA beaches during 2017 identified

Infrastructure & Utilities
Residents are losing the war on waste in PE's Jacksonville

Circular Economy & Waste Management
Illegal dumping sites turned into children's playgrounds




Circular Economy & Waste Management
PE municipality clears hazardous rubbish dumps

ESG & Sustainability
A fresh focus on new approaches to recycling tyres is needed


Smart Buildings & Cities
Smart cities need to include the concept of smart citizens

Circular Economy & Waste Management
How clean are Cape Town's rivers?


Infrastructure, Innovation & Technology
Festival aims to create awareness of water scarcity

Environment & Natural Resources
E.coli alert raises big stink at Clifton


